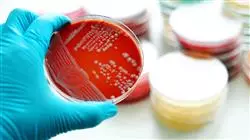

Universitäre Qualifikation
Die größte Fakultät für Pharmazie der Welt"
Präsentation
Aktualisieren Sie sich mit dieser akademischen Gelegenheit in der Erforschung der autochthonen Mikrobiota des menschlichen Körpers“

Die Forschung zu Mikrobiota und Mikrobiom hat in den letzten Jahrzehnten erhebliche Fortschritte gemacht. Diese Mikroorganismen sind an zahlreichen biologischen Prozessen beteiligt, darunter die Verdauung, der Stoffwechsel, das Immunsystem und die Entwicklung des zentralen Nervensystems. Darüber hinaus hat sich gezeigt, dass Dysbiose oder ein Ungleichgewicht der Mikroben mit verschiedenen Krankheiten wie Magen-Darm-Erkrankungen, Stoffwechsel-, Autoimmun- und neuropsychiatrischen Erkrankungen in Verbindung gebracht werden.
Da sich immer mehr Fachkräfte mit wirksamen Strategien zur Modulation der Mikrobiota befassen, hat TECH diesen Universitätskurs vorbereitet. Er wird dem Pharmazeuten einen tiefen Einblick in die Funktionsweise von Mikroorganismen und deren Beteiligung an der Gesundheit vermitteln. Der Lehrplan des Programms deckt daher wichtige Punkte ab, wie die Schlüsselkonzepte Symbiose, Kommensalismus, Mutualismus und Parasitismus. Auch der Einfluss von Ernährung, Lebensstil und Antibiotikatherapie wird ausführlich erörtert, und innovative Themen wie Fäkaltransplantation und die Interaktion zwischen Epigenetik und Mikrobiota werden erforscht.
Dieser Studiengang ist zu 100% online, so dass die Studenten jederzeit und von überall auf die akademischen Ressourcen zugreifen können. Dabei können sie sich auf die Erfahrung eines Lehrkörpers stützen, der sich aus Experten der Mikrobiologie und anderer verwandter Fachgebiete zusammensetzt, die eine solide und aktuelle Fortbildung vermitteln. Darüber hinaus ist ein renommierter internationaler Experte mit umfassender Erfahrung in der Erforschung der menschlichen Mikrobiota dabei. Dieser renommierte Spezialist ist für die Entwicklung einer exklusiven Masterclass während dieses Studiengangs verantwortlich.
Bilden Sie sich durch eine fundierte Masterclass und unter der akademischen Leitung eines hervorragenden internationalen Gastdirektors dank dieses TECH-Programms fort“
Dieser Universitätskurs in Mikrobiota und Mikrobiom enthält das vollständigste und aktuellste wissenschaftliche Programm auf dem Markt. Die wichtigsten Merkmale sind:
- Die Entwicklung von Fallstudien, die von Experten auf dem Gebiet der Mikrobiota und des Mikrobioms vorgestellt werden
- Der anschauliche, schematische und äußerst praxisnahe Inhalt vermittelt alle für die berufliche Praxis unverzichtbaren wissenschaftlichen und praktischen Informationen
- Die praktischen Übungen, bei denen der Selbstbewertungsprozess zur Verbesserung des Lernens durchgeführt werden kann
- Sein besonderer Schwerpunkt liegt auf innovativen Methoden
- Theoretische Lektionen, Fragen an den Experten, Diskussionsforen zu kontroversen Themen und individuelle Reflexionsarbeit
- Die Verfügbarkeit des Zugriffs auf die Inhalte von jedem festen oder tragbaren Gerät mit Internetanschluss
Werden Sie Experte für die Beratung Ihrer Patienten zu Gewohnheiten, die Dysbiose verhindern“
Zu den Dozenten des Programms gehören Fachkräfte aus der Branche, die ihre Berufserfahrung in diese Fortbildung einbringen, sowie renommierte Fachleute von Referenzgesellschaften und angesehenen Universitäten.
Die multimedialen Inhalte, die mit der neuesten Bildungstechnologie entwickelt wurden, werden der Fachkraft ein situiertes und kontextbezogenes Lernen ermöglichen, d. h. eine simulierte Umgebung, die eine immersive Fortbildung bietet, die auf die Ausführung von realen Situationen ausgerichtet ist.
Das Konzept dieses Programms konzentriert sich auf problemorientiertes Lernen, bei dem die Fachkraft versuchen muss, die verschiedenen Situationen aus der beruflichen Praxis zu lösen, die während des gesamten Studiengangs gestellt werden. Zu diesem Zweck wird sie von einem innovativen interaktiven Videosystem unterstützt, das von renommierten Experten entwickelt wurde.
Es handelt sich um eine Beherrschung der Interaktion zwischen Epigenetik und Mikrobiota, wobei nützliche Fallstudien gelöst und anhand interaktiver Diagramme rekapituliert werden"

Das Programm entwickelt fortschrittliche pharmazeutische Strategien zur Aufrechterhaltung der Darmhomöostase auf der Grundlage von Probiotika, Präbiotika oder Synbiotika"
Lehrplan
Der Lehrplan wurde so konzipiert, dass er perfekt auf die Bedürfnisse und das unterschiedliche Lerntempo der Studenten abgestimmt ist. Darüber hinaus ist die Relearning-Methode in jedes der Fächer integriert, was eine bessere Beibehaltung der Konzepte und einen effektiveren Bildungszyklus ermöglicht. Dies erfolgt mit Hilfe hochdynamischer akademischer Ressourcen wie Erklärungsvideos, interaktiven Diagrammen, Fallstudien, Fragebögen und ergänzender Literatur. Diese stehen den Studenten 24 Stunden am Tag auf dem virtuellen Campus zur Verfügung.

Ein Lehrplan, der alle allgemeinen Aspekte der Eubiose und Dysbiose der mikrobiellen Einheiten des menschlichen Körpers behandelt“
Modul 1. Mikrobiota. Mikrobiom. Metagenomik
1.1. Definition und Beziehung zwischen ihnen
1.2. Zusammensetzung der Mikrobiota: Gattungen, Arten und Stämme
1.2.1. Gruppen von Mikroorganismen, die mit der menschlichen Spezies interagieren: Bakterien, Pilze, Viren und Protozoen
1.2.2. Schlüsselbegriffe: Symbiose, Kommensalismus, Mutualismus, Parasitismus
1.2.3. Einheimische Mikrobiota
1.3. Verschiedene menschliche Mikroben. Allgemeine Informationen über Eubiose und Dysbiose
1.3.1. Gastrointestinale Mikrobiota
1.3.2. Orale Mikrobiota
1.3.3. Hautmikrobiota
1.3.4. Mikrobiota des Atemtrakts
1.3.5. Mikrobiota des Harntrakts
1.3.6. Mikrobiota des Fortpflanzungstraktes
1.4. Faktoren, die das Gleichgewicht und Ungleichgewicht der Mikrobiota beeinflussen
1.4.1. Ernährung und Lebensstil. Darm-Hirn-Achse
1.4.2. Antibiotika-Therapie
1.4.3. Interaktion zwischen Epigenetik und Mikrobiota. Endokrine Disruptoren
1.4.4. Probiotika, Präbiotika, Symbiotika. Konzepte und Allgemeinheiten
1.4.5. Fäkaltransplantation, jüngste Fortschritte
Die neuesten Fortschritte in der Antibiotikatherapie durch eine einzigartige akademische Qualifikation. Schreiben Sie sich jetzt ein!"
Universitätskurs in Mikrobiota und Mikrobiom
Die Mikrobiota und das Mikrobiom sind Begriffe, die in den letzten Jahren im Bereich der Gesundheit stark an Bedeutung gewonnen haben. Die Mikrobiota bezieht sich auf die Gesamtheit der Mikroorganismen, die einen Organismus bewohnen, während sich das Mikrobiom auf die Gesamtheit seiner Gene bezieht. Diese Mikroorganismen spielen u. a. eine wichtige Rolle bei der Regulierung des Immunsystems und der Verdauung. Daher ist die Kenntnis der Zusammensetzung der Mikrobiota und des Mikrobioms von entscheidender Bedeutung, um den Gesundheitszustand einer Person zu verstehen und im Falle von damit zusammenhängenden Pathologien eingreifen zu können. In diesem Sinne hat TECH einen Universitätskurs entwickelt, der darauf abzielt, Apothekern das nötige Wissen zu vermitteln, um die Mikrobiota und das Mikrobiom und ihre Auswirkungen auf die Gesundheit eingehend zu verstehen. Es handelt sich um eine Ausbildung, die sich mit den molekularen und zellulären Grundlagen der Mikrobiota und des Mikrobioms befasst und Themen wie seine Zusammensetzung, seine Dynamik und seine Beziehung zur Ernährung behandelt.
Eine sehr gefragte Spezialisierung
Darüber hinaus befasst sich dieser Universitätskurs in Mikrobiota und Mikrobiom auch mit der Rolle der Mikrobiota bei verschiedenen Pathologien wie entzündlichen Darmerkrankungen, Krebs und Fettleibigkeit und bietet Instrumente und Strategien für ihren pharmakologischen Ansatz. In diesem Zusammenhang liegt der Schwerpunkt auf der Verwendung von Probiotika und Präbiotika sowie auf anderen Ernährungsmaßnahmen wie der Mittelmeerdiät. Kurz gesagt, dieses Studienprogramm wird es den Apothekern ermöglichen, sich auf einem sich ständig weiterentwickelnden Gebiet den neuesten Wissensstand anzueignen und so in der Lage zu sein, ihre Patienten umfassender und effizienter zu beraten. Außerdem können sie sich damit auf ein aufstrebendes Gebiet spezialisieren, das in den kommenden Jahren voraussichtlich sehr gefragt sein wird.